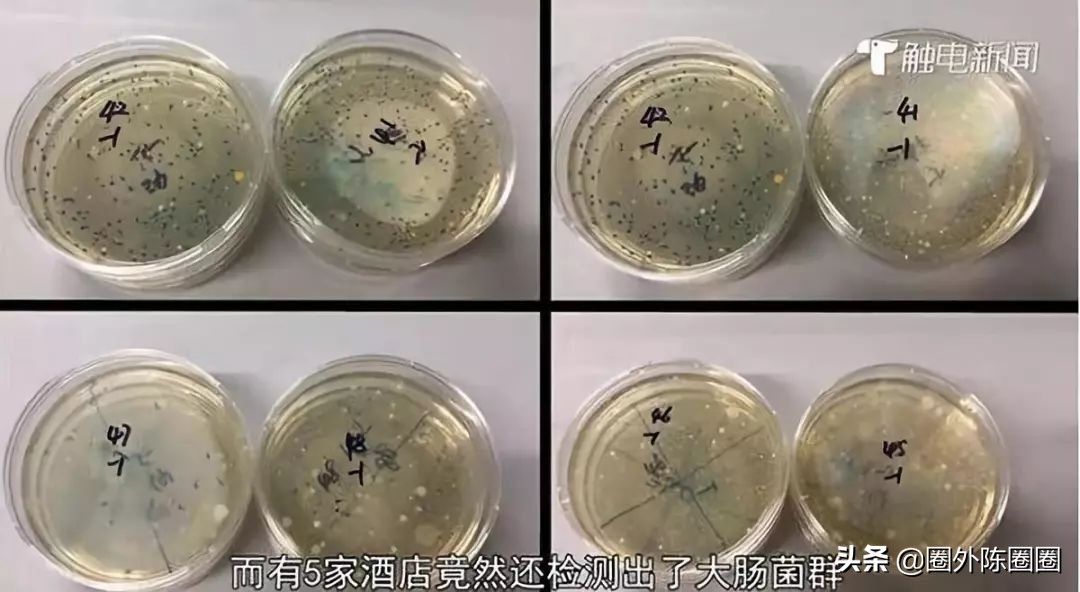
生活中有哪些常见凶险的致病菌,防控病原菌受到污染的措施主要有

东野奎吾在《白夜行》里说:“唯太阳和人心不可直视。”
还记得那些曾经被报出来的酒店环境有多脏吗?一些中国酒店洗漱用具的制造流程,可真是晃瞎了全中国人的眼。
牙刷制作不消毒,洗漱用品用廉价原料勾兑…

早些时候,许多五星级酒店被爆出服务人员并未按流程操作,他们使用马桶刷刷杯子,不更换新床单…

之后,调查中10家酒店,有4家细菌总量超标,5家酒店竟检测出了致病菌。
还有更恶心的是,酒店烧水壶里竟然被放入了用过的卫生巾,其中包装袋还留在垃圾桶里,可见放入卫生巾的人一定是刚刚退房的客人。随后酒店查询了登记入住信息,结果发现入住该房间的是两名打扮时髦的年轻女子,两名女子在退房之后,无其他人员进入。

常见致病菌
- 金黄色葡萄球菌
金黄色葡萄球菌在自然界中无处不在,空气、水、灰尘及人和动物的排泄物中都可找到。因此,食品受其污染的机会很多。美国疾病控制中心报告,由金黄色葡萄球菌引起的感染占第二位,仅次于大肠杆菌。金黄色葡萄球菌的流行病学一般有如下特点:季节分布,多见于春夏季;中毒食品种类多,如奶、肉、蛋、鱼及其制品。此外,剩饭、油煎蛋、糯米糕及凉粉等引起的中毒事件也有报道。食品加工人员、炊事员或销售人员带菌,造成食品污染;食品在加工前本身带菌,或在加工过程中受到了污染,产生了肠毒素,引起食物中毒;熟食制品包装不严,运输过程受到污染;奶牛患化脓性乳腺炎或禽畜局部化脓时,对肉体其他部位的污染。引起上吐下泻。
是人类化脓感染中最常见的病原菌,可引起局部化脓感染,我们平时伤口感染,最多见的就是这个菌引起的。

金黄色葡萄球菌
防止方法:防止金黄色葡萄球菌肠毒素的生成,应在低温和通风良好的条件下贮藏食物,以防肠毒素形成;在气温高的春夏季,食物置冷藏或通风阴凉地方也不应超过6h,并且食用前要彻底加热。保持皮肤清洁,万一出现伤口,立刻清创、避免感染。
出门在外,尤其注意不要吃不新鲜的食物哦!
- 大肠杆菌
其实,大肠杆菌并不都是坏的。它是人和动物肠道中的正常栖居菌,婴儿出生后即随哺乳进入肠道,与人终身相伴,几乎占粪便干重的1/3。

大肠杆菌
正常情况下,大多数大肠杆菌是非常安分守己的,他们不但不会给我们的身体健康带来任何危害,反而还能竞争性抵御致病菌的进攻,同时还能帮助合成维生素K2,与人体是互利共生的关系。只有在机体免疫力降低、肠道长期缺乏刺激等特殊情况下,这些平日里的良民才会兴风作浪,移居到肠道以外的地方,例如胆囊、尿道、膀胱、阑尾等低,造成相应部位的感染或全身播散性感染。以及急性腹泻等等,因此,大部分大肠杆菌通常被看作机会致病菌。
可通过饮用受污染的水或进食未熟透的食物(特别是牛肉,鸡肉,牛奶,奶制品等)而感染。此外,若个人卫生欠佳,亦可能会通过人传人的途径,或经进食受粪便污染的食物而感染该种病菌。
防止方法:饭前便后,洗手。做到食物加工全熟再食用,.食物应彻底清洗。食水应采用自来水,并最好煮沸后才饮用。应从可靠的地方购买新鲜食物,不要光顾无牌小贩。不要吃不干净的东西。 体质弱、衰老、出差、旅游等应激状态下,可以补食乳酸菌,预防大肠杆菌的发病。
注意卫生,才是王道!
- 军团菌
军团菌是隐藏在空调制冷装置中的致病菌,随冷风吹出浮游在空气中,吸入人体后会出现上呼吸道感染及发热的症状,严重者可导致呼吸衰竭和肾衰竭。军团菌最早是由于部队室内密闭作业,导致群体发生上呼吸道感染而得名。军团病是一种非常严重的、有时可以致命的肺炎。军团病是由军团杆菌引起,这种细菌产生在自然环境中,在温水里及潮热的地方蔓延。人工供水系统有时也能为军团杆菌的大量繁殖提供生存环境。这些系统包括淋浴器、矿泉池、喷泉以及空调设备的冷却水塔。人们通常是由于呼吸了被军团杆菌污染的水源散发的水雾而传染上军团病的。2000年,有学者对北京14家四五星级的大饭店进行调查,结果显示,其中12家的空调冷却塔存在军团菌污染。

军团菌
防止方法:普通人接触到的机会不多,不过,空调定时清洗,适当开窗通风, 永远不会错。
- 沙门杆菌
.鸡蛋可能会被沙门杆菌污染。尤其是生鸡蛋。
沙门杆菌,也称沙门氏菌(Salmonella),“杆”说的形态,“氏”指的是命名人。1885年,史密斯(Theobald Smith )第一次分离出了沙门氏菌,而后他的领导Daniel Elmer Salmon,用自己的名字命名了它。
它会引发:肠热症:是伤寒病和副伤寒病,以及急性肠炎(食物中毒):是最常见的沙门氏杆菌感染。

沙门杆菌
防止方法:食物加热,全熟,尤其是鸡蛋,是不是很简单!
出门在外,我们能怎么做?
1、房间内要经常开窗换气
一般旅社和宾馆,普通房间往往是4~8个人同住一室,人多,空气比较污浊,再加上有些人还吸烟,就容易交叉感染疾病。即使住的是条件较好的旅社或高级宾馆,卧室备有空调,但也常门窗紧闭,气温恒定,室内空气得不到流通,十分适合某些病毒或细菌生长繁殖。加之室内外温差较大,很容易使住在里面的人感到头昏、乏力、鼻塞,甚至感冒,患上"空调综合症"。为了预防疾病,旅客们应每天定时打开门窗通气,特别是夜间就寝前和早晨起床后,一定要开窗通气20分钟左右,使空气对流,以保持室内空气的清洁度。

2.洗漱用具要自备,绝不使用盆浴
住旅社或宾馆,每天免不了要洗脸、洗澡、漱口。这时要注意不要使用公共洗漱用具,如毛巾、浴巾,漱口杯、面盆等。有的人图方便,喜欢使用公共洗脸用具,以为只要洗一洗或冲一冲就行了,却不知这样做并不能达到消毒的要求,仍存在传染疾病的可能。洗澡应采取淋浴,绝对要避免染交叉感强的盆浴。洗脸也以在水龙头下用流水冲洗为宜。
一般的旅行者,出门必带:牙膏、牙刷、毛巾、漱口杯、睡衣、床单、浴缸消毒剂、一次性马桶垫、消毒湿巾。

3、上厕所尽量使用蹲式而不用坐式
住宿条件较好的旅社、宾馆,客房多用单独的卫生间,设有坐式马桶。这种坐式马桶,最容易使人感染痢疾、伤寒、淋病、梅毒,疥疮等传染病。为安全起见最好不用房间里的卫生间,最好用每层楼中另设置的公用厕所,使用其中的蹲式便池。万一找不到蹲式厕所,可用清洁的卫生纸垫在马桶的木垫上再用。同时注意在接触抽水手柄或按钮时,要用小块卫生纸包裹后再用,或用后用肥皂洗手,以免手被污染而得病。手不要乱摸。

4、不要使用公共碗筷就餐
在旅社或宾馆的餐厅就餐,尤其是集体用餐,服务员准备了碗、筷、杯、盘、毛巾等,尽管经过了清洗或一般消毒,但这些餐具传来递去仍然可能成为传播痢疾、伤寒、病毒性肝炎的重要媒介。因此,要尽可能避免共同在一个盘里夹菜,应采用"分餐制",每人一份饭菜,或者自备餐具。不得不集体用餐时,也要使用公筷或公勺,把菜拨在自己盘里,然后用自己的筷勺来吃。
.

5、不要裸身睡觉
有的人习惯夜间裸身或仅穿短*裤内**睡觉,这在住旅社、宾馆时,是切切不可以的。这样很容易感染多种传染病。因此,如果你担心酒店被褥的卫生,那就穿上自己的长睡衣和袜子睡觉。 如果还对酒店的卫生质疑,可以带上自己的床单,就不用担心隐藏的灰尘和细菌了。
6、行李不要放地上
行李放在地面上很容易受到各种小虫的入侵,尤其是铺有地毯的房间。行李尽量放在桌子上,并记得拉上拉链。为了保险起见,可以给行李套个塑料袋。换房间的话尽量离远点,一旦发现确凿证据表明房间存在问题,立即换房间。新房间至少应该隔2层楼,因为小虫子很可能沿着墙板或电气线路传播。

祝大家疫后复工快乐!
参考文献
[1] 大V花总的三次曝光:表、世奢会和酒店_七环视频_澎湃新闻[EB/OL]. [2018-12-09].
[2] 这些快捷酒店细菌超标!城市便捷、汉庭等酒店还检出致病菌!-腾讯新闻[EB/OL]. [2018-12-09].
[3] 李凡, 徐志凯. 医学微生物学[M]. 北京: 人民卫生出版社, 2013.
[4] 煎蛋网. 餐厅食物被粪便污染,导致爆发大肠杆菌疫情[EB/OL]. 煎蛋网, [2018-12-09].
[5] 你所不知道的肠道菌群----中国科学院微生物研究所[EB/OL]. [2018-12-09].
[6] 中国营养学会. 中国居民膳食营养素参考摄入量(2013版)[M]. 科学出版社, 2014.
[7] DONDERO JR T J, RENDTORFF R C, MALLISON G F等. An outbreak of Legionnaires’ disease associated with a contaminated air-conditioning cooling tower[J]. New England Journal of Medicine, 1980, 302(7): 365–370.
[8] 罗世华. 一起 57 例 “空调病” 暴发的情况调查[J]. 解放军预防医学杂志, 2002, 20(4): 280–281.
[9] 裴晓旻, 裴红生, 黎新宇等. 北京市大饭店空调冷却塔军团菌污染现况及人群感染水?…[J]. 中华流行病学杂志, 2000, 21(4): 289–291
圈外陈圈圈,我在这里,希望大家都能有个好身体!